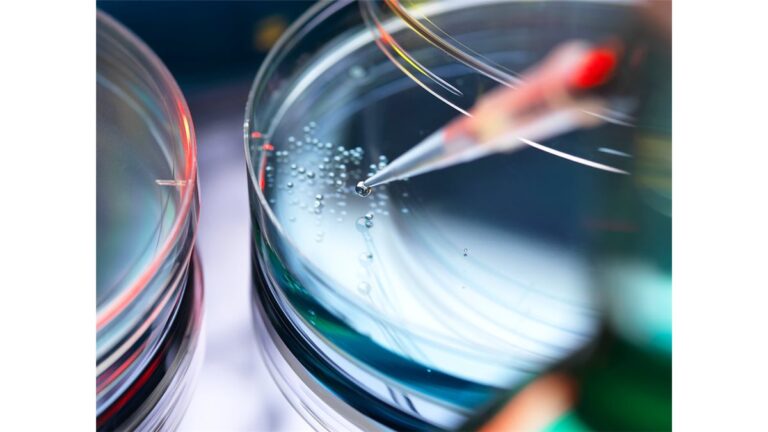
Estudo de Biologia para ENEM

Exemplos Práticos para Mandar Bem na Prova
Agora, além de revisar os conceitos fundamentais, vamos explorar exemplos que ilustram como esses conhecimentos podem aparecer no ENEM, ajudando você a entender como aplicar a teoria, na prática.
1. Estrutura celular e bioquímica da vida
Exemplo prático:
Imagine que uma questão traga o seguinte experimento:
Um cientista observou células vegetais e animais ao microscópio e anotou as seguintes características:Célula A: Presença de mitocôndrias e vacúolos grandes.Célula B: Presença de mitocôndrias, ausência de vacúolos grandes e presença de centríolos.
Com base nessas observações, você deve identificar:
A célula A como uma célula vegetal, já que vacúolos grandes são típicos das plantas.
A célula B como uma célula animal, que possui centríolos, mas não vacúolos grandes.
Dica prática:
Pratique identificando as funções e características das organelas. No ENEM, questões assim pedem que você relacione estruturas com suas funções e a classificação das células.
2. Genética e Biotecnologia
Exemplo prático:
Suponha que o enunciado da questão fale sobre um cruzamento entre duas plantas de ervilha, uma heterozigota para a cor amarela (Aa) e outra homozigota recessiva para a cor verde (aa). A questão pede a probabilidade de nascerem plantas com ervilhas verdes.
Monte o quadrado de Punnett:
Resultado: 50% de ervilhas amarelas (Aa) e 50% de ervilhas verdes (aa).
Dica prática:
Entender como montar e interpretar esses cruzamentos é fundamental. Pratique cruzamentos com diferentes tipos de herança, como codominância e herança ligada ao sexo.
3. Ecologia e Sustentabilidade
Exemplo prático:
Uma empresa instalou uma fábrica próxima a um rio. Após alguns anos, foi observada a diminuição de peixes e o aumento de algas na água. A questão pede que você explique o fenômeno com base no ciclo do nitrogênio.
Esse fenômeno pode ser explicado pela eutrofização, que ocorre quando há excesso de nutrientes (como nitratos e fosfatos) no rio, aumentando a proliferação de algas. Quando essas algas morrem, há uma decomposição intensa que consome oxigênio, prejudicando os peixes.
Dica prática:
Estude o ciclo dos nutrientes e entenda como poluentes afetam os ecossistemas. O ENEM adora questões com enfoque ambiental, como poluição e aquecimento global.
4. Evolução
Exemplo prático:
A resistência de bactérias aos antibióticos tem aumentado. Em uma questão, o ENEM pode pedir que você relacione esse fato à teoria de Charles Darwin.
A resposta correta deve mencionar a seleção natural: as bactérias mais resistentes sobrevivem ao antibiótico e passam suas características genéticas às próximas gerações, aumentando a prevalência de bactérias resistentes.
Dica prática:
Quando o ENEM aborda evolução, ele frequentemente utiliza exemplos atuais, como a resistência a antibióticos ou mudanças nas populações de animais devido a interferências humanas.
5. Fisiologia Humana
Exemplo prático:
Um atleta sentiu um aumento nos batimentos cardíacos e na respiração durante um treino intenso. A questão pede que você explique por que isso acontece em termos fisiológicos.
A resposta envolve o sistema cardiovascular e respiratório. Durante o exercício, há um aumento na demanda de oxigênio para os músculos. O coração bate mais rápido para bombear mais sangue (e, portanto, mais oxigênio), enquanto o sistema respiratório acelera para fornecer mais oxigênio e eliminar o excesso de dióxido de carbono.
Dica prática:
No ENEM, você pode encontrar gráficos ou textos que descrevem mudanças nos sistemas do corpo. Esteja preparado para identificar qual sistema está em ação e como eles colaboram para manter a homeostase.
Resumo de Dicas Gerais para Biologia no Enem:
Interprete gráficos: O ENEM adora dados, tabelas e gráficos. Muitas questões pedirão que você analise uma situação, então pratique lendo e interpretando essas representações.
Contextualize os conteúdos: Relacione a biologia aos desafios atuais, como doenças, avanços tecnológicos, e questões ambientais.
Foco na interdisciplinaridade: Fique atento às questões que misturam biologia com química e geografia, especialmente em temas como biotecnologia e ecossistemas.
✨🖋️📜 Pronto! Com esses exemplos práticos, você consegue visualizar melhor os conceitos e suas aplicações. Agora é só continuar revisando e praticando Biologia para o ENEM!
Quando a Educação Sangra
Sisu 2025: A porta de entrada para o futuro dos estudantes brasileiros